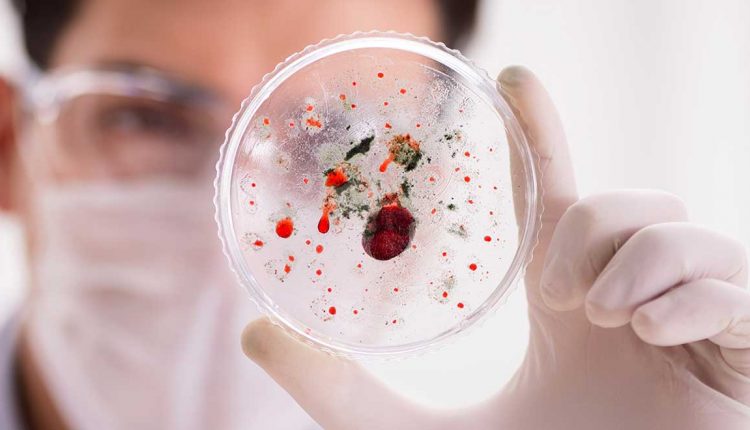

მაღალი სიცხე, ღებინება, ნაწლავთა გახშირებული მოქმედება – რა სიმპტომები ახასიათებს სალმონელოზს, რომელიც ზაფხულობით აქტიურდება
ზაფხულის პერიოდში ნაწლავური ინფექციების რაოდენობა მკვეთრად იზრდება ხოლმე და კლინიკებსაც ბევრი ადამიანი მიმართავს. მათ შორის, სალმონელოზიცაა. სხვადასხვა სამედიცინო ჯგუფში მშობლები წერენ, რომ მათ ირგვლივ ბევრი შემთხვევაა და მძიმედ მიმდინარეობს. ციციშვილის სახელობის ბავშვთა ახალი კლინიკის სამედიცინო დირექტორს მაია ჩხაიძეს ვკითხეთ, როგორია მათ კლინიკაში სალმონელოზით მიმართვიანობა და რა შემთხვევაში უნდა იყვნენ მშობლები განსაკუთრებით ყურადღებით:
– კლინიკაში ბაქტერიული ნაწლავური ინფექციით სულ რამდენიმე პაციენტი მკურნალობს და წინა წელთან შედარებით, შემთხვევები გაზრდილი არ არის. ამ ეტაპზე რესპირატორული ვირუსული ინფექციებით უფრო მეტი ბავშვია მოთავსებული. წელს რესპირატორული
ინფექციების სეზონი გახანგრძლივდა, რადგანაც, როგორც წესი, ამ პერიოდისათვის ამხელა მომართვიანობა დამახასიათებელი არ არის. განსაკუთრებით, წლამდე ასაკის ბავშვებში ბრონქიოლიტი ხდება მომართვიანობის მიზეზი. რაც შეეხება სალმონელოზს, იგი ბაქტერიული ნაწლავური ინფექციაა, რომელიც 2 დღემდე გრძელდება. ძირითადად, დაინფიცირება დაბინძურებული საკვების მიღების შედეგად ხდება. იწყება ინტოქსიკაცია, ღებინება, ცხელება და ნაწლავთა გახშირებული მოქმედება. თუ ღებინება შეუპოვარია და პაციენტი სითხეებს ვერ იღებს, მაშინ კლინიკაში უნდა გადაიყვანოთ, რადგანაც სითხეებითა და ელექტროლიტებით შევსება აუცილებელია. ასევე, საჭიროა ნაწლავური ბაქტერიული ინფექცია ნაწლავური ვირუსული ინფექციისგან განვასხვავოთ და ამისთვის კვლევის ჩატარებაა საჭირო, რაც კლინიკაში ხდება. ძირითადად პაციენტები სითხეებითა და ელექტროლიტებით შევსების მიზნით მოგვმართავენ.
ექიმი ინფექციონისტი ალექსანდრე გოგინავა აცხადებს, რომ ზაფხულის სეზონისათვის კლინიკაში ნაწლავური ინფექციებით მიმართვიანობის გაზრდა დამახასიათებელია და გვისახელებს კონკრეტულ რეკომენდაციებს, რა უნდა გავაკეთოთ, რომ ინფიცირებისგან თავი დავიცვათ და რა შემთხვევაში უნდა მივმართოთ საავადმყოფოს:
– ზოგადად, სალმონელოზის შემთხვევები ზაფხულის პერიოდში იზრდება და ამაში რაიმე სიახლე არ არის. სალმონელოზით ინფიცირება ძირითადად მაშინ ხდება, როდესაც ადამიანები მალფუჭებად პროდუქტებს მიირთმევენ, რომლებიც წესების დარღვევითაა შენახული. ეს შეიძლება იყოს კვერცხი, მაიონეზი და ასე შემდეგ. აქედან გამომდინარე, ძალიან მნიშვნელოვანია, რომ ზაფხულის პერიოდში მალფუჭებადი პროდუქტები წესების ზედმიწევნით დაცვით შევინახოთ. სალმონელოზის შემთხვევები განსაკუთრებით საყურადღებო ბავშვთა ასაკშია. ამ ასაკობრივ კატეგორიაში ჩვილ ბავშვებს გამოვყოფდი. ასევე, განსაკუთრებით საყურადღებოა ასაკოვან ადამიანებში და მათთან, ვისაც იმუნოდეფიციტი აქვთ. მნიშვნელოვანია, რომ მალევე მოხდეს ჯანმრთელობის მდგომარეობის სწორი შეფასება, რადგანაც ზაფხულში დეჰიდრატაციის რისკები საკმაოდ მაღალია, რომლის განვითარებაც განსაკუთრებით სწრაფად ბავშვებში მიმდინარეობს. თუ ბავშვი შესაბამისი რაოდენობის სითხესა და ელექტროლიტებს, საკვებს არ იღებს, აუცილებელია პედიატრს ან ინფექციონისტს მიმართოთ, რათა დროულად შეფასდეს მდგომარეობა და გადაწყდეს, სჭირდება სპეციფიკური მკურნალობა, თუ არა. სალმონელოზის სამკურნალოდ გართულებულ და მძიმე შემთხვევებში ანტიბიოტიკები გამოიყენება, მსუბუქ შემთხვევაში – არა. ამიტომ, მკურნალობა დამოკიდებულია პაციენტის სიმძიმეზე, ბავშვის ასაკზე და მის იმუნურ სტატუსზე. სალმონელოზი შესაძლოა დიდებშიც მძიმედ წარიმართოს, ამიტომ, პრევენციული ღონისძიებები ყველასთვის ერთია – უნდა მოვერიდოთ მალფუჭებად პროდუქტებს, რომლებიც წესის დარღვევითაა შენახული. ასევე, ყოველთვის დავხედოთ ვადას. კვერცხი მინიმუმ ნახევარი საათი უნდა მოვხარშოთ იმისთვის, რომ სალმონელოზის განვითარების რისკები თავიდან ავირიდოთ. ე.წ. თოხლოდ მოხარშული კვერცხი ნაკლებად უნდა გამოვიყენოთ. ზაფხულში ნაწლავური ინფექციები საკმაოდ ხშირია და ჰიგიენური ნორმებიც ზედმიწევნით უნდა დავიცვათ, ხელები ხშირად დავიბანოთ. საკვები პროდუქტები სწორად შევინახოთ და თუ მაინც დაგვემართება ნაწლავური ინფექცია, მათ შორის, სალმონელოზი, დავაკვირდეთ რამდენიმე ფაქტორს: რამდენად სწორად და ადეკვატურად ვიღებთ სითხეებს, რადგანაც ნაწლავური ინფექციების დროს დეჰიდრატაცია ყველაზე უფრო ხშირი და საყურადღებო გართულებაა. თუ დაავადება მაღალი ცხელებით მიმდინარეობს, რომელიც ძლიერ სისუსტეს, წნევის დაქვეითებას იწვევს, გვიჭირს გადაადგილება, გვაქვს პირის სიმშრალე, ასეთ დროს მნიშვნელოვანია, რომ ექიმს მივმართოთ.
წყარო: https://www.mshoblebi.ge